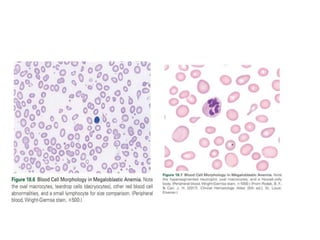

Megaloblastic anemias are disorders characterized by impaired DNA synthesis due to deficiencies in vitamin B12 and folic acid, leading to the presence of megaloblastic cells in the bone marrow and macrocytic anemia. The document outlines various causes of these deficiencies, including dietary factors, malabsorption, drug-induced effects, and genetic conditions, as well as clinical features and laboratory diagnostics for megaloblastic anemia. Treatment varies based on the underlying cause, with vitamin B12 and folic acid supplementation being the primary interventions.